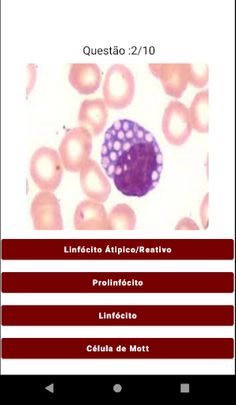
HemoQuiz: Quiz Hematologia - Screenshot 4

Game overview
Quiz com perguntas sobre estruturas presentes na leitura de lâmina do hemograma (Leucócitos, Poiquilócitos, plaquetas).
Developer
More games by Haldane Padilha

Quiz com perguntas sobre estruturas presentes na leitura de lâmina do hemograma (Leucócitos, Poiquilócitos, plaquetas).
Skich uses cookies and similar technologies to provide, improve, secure and analyse our services. By clicking "Accept All", you agree to let us use our own and third party cookies according to Cookies Policy.